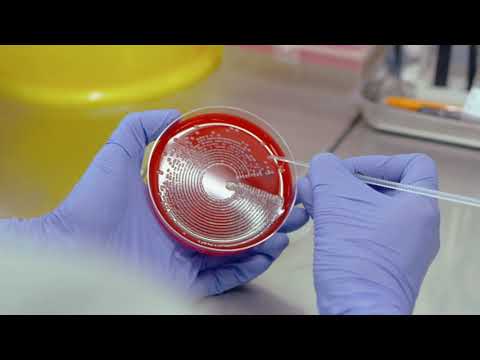

Course Summary
During this interdisciplinary course, you will learn both the theoretical and practical aspects of chemical, biochemical and microbiological analysis. In first year, you’ll gain essential background knowledge in chemistry, biology, mathematics and physics, and get hands-on laboratory experience. From second year on, you’ll focus on analytical science and from third year, you’ll specialise in either chemical or biological analysis.
Academic Spotlights - A Certain Chemistry
As an analytical chemist, Dr Blánaid White Lecturer, School of Chemical Sciences and Principal Investigator, National Centre for Sensor Research and DCU Water Institute is outstanding in her field; quite literally, as her work involves her looking at levels of organic matter in soil and how it affects the quality of crops. Click HERE to find out more.
College Link
Podcasts
Jennifer O'Connell, Final year Analytical Science student (13mins 23secs)
College Virtual Tour
Career Sectors
This course prepares you for working in the Career Sectors below. Follow the links to get a fuller understanding of the sectors you are preparing for.
Language Options
Language options with this course
The following language options are available to study as part of this programme:
* Time abroad utilising this language
Disclaimer: Details subject to change - always check with the college.
Note: It may also be possible to do an Erasmus+ Programme allowing you to study abroad for a
period of at least 2 months to 12 months. This study can be through English or through your
language of choice � please check with your course coordinator to see if this is possible
for this course.
Entry Requirements
Disclaimer: Details subject to change - If this is a course you are considering applying for you should check on the Colleges' website to ensure you have the latest entry requirements information.
If you believe the data above to be incorrect, please let us know at [email protected] - thank you.
PLC Progression Links
PLC courses leading to the following QQI Major Awards may be used for entry into this course.
Search for PLC Courses offering these awards (Click on the Codes)
| PLC Codes | Award Title |
| 5M3807 | Laboratory Techniques |
This Information is Correct for 2026 Entry

Points Calculator for QQI Awards:
Details of the QQI scoring system and a points calculator can be found
HERE
The Student
Career Interests
This course is typically suited for people with the following Career Interests. If these interests do not describe you, this course may prepare you for work you may not find satisfying.
Investigative
The Investigative person will usually find a particular area of science to be of interest. They are inclined toward intellectual and analytical activities and enjoy observation and theory. They may prefer thought to action, and enjoy the challenge of solving problems with sophiscticated technology. These types prefer mentally stimulating environments and often pay close attention to developments in their chosen field.
Career Progression
Past graduates have gained a variety of positions within Ireland’s growing pharmaceutical and biopharmaceutical industry – in areas such as quality control, product research and development and testing.
Other opportunities include manufacturing industries, agricultural fertiliser production and fine chemicals production, environmental monitoring, food quality testing and research.
Further Research
DISCLAIMER: These links are to official sources of information for this course - we accept no responsibility for the information on them.